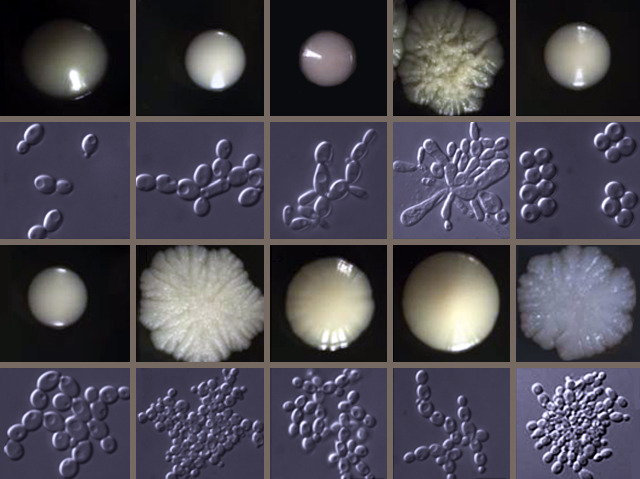

24 July 2014
Library of Fungus
The fungus Candida glabrata is an increasingly common cause of an infection called candidiasis, which is usually superficial and unpleasant – oral thrush, for instance – but can be life threatening in people with compromised immune systems. This particular fungal invader is highly resistant to drugs, but it doesn’t secrete the enzymes usually associated with resilience. To figure out why it’s such a formidable foe, researchers built a library of over 600 mutant C. glabrata strains, each lacking a specific gene. Pictured are the individual cells and the colonies they form. Top left is the wild-type strain and the others are deletion strains. By studying the various strains as they were exposed to stresses, including anti-fungal drugs, the scientists identified genes involved in C. glabrata’s fitness and resilience. Their deletion library could potentially help to reveal weak points that might be exploited with new anti-fungal drugs.
Written by
Search The Archive
Submit An Image
Like us on Facebook
Follow on Twitter
Follow on Tumblr
Follow on Instagram
What is BPoD?
BPoD stands for Biomedical Picture of the Day. Managed by the MRC Laboratory of Medical Sciences until Jul 2023, it is now run independently by a dedicated team of scientists and writers. The website aims to engage everyone, young and old, in the wonders of biology, and its influence on medicine. The ever-growing archive of more than 4000 research images documents over a decade of progress. Explore the collection and see what you discover. Images are kindly provided for inclusion on this website through the generosity of scientists across the globe.
BPoD is also available in Catalan at www.bpod.cat with translations by the University of Valencia.








